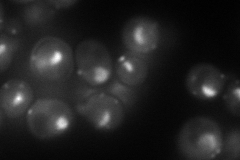
YPL126W
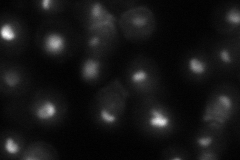
YPL126W
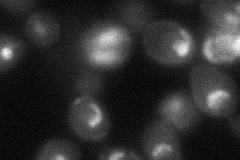
YPL126W
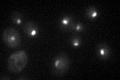
YPL126W

View description
U3 snoRNP protein, component of the small (ribosomal) subunit (SSU) processosome containing U3 snoRNA; required for the biogenesis of18S rRNA
Localization:
Intensity:
Fold change:
Significance:
-
C’ GFP library in SD

nucleolus95.96 -
N' NOP1pr-GFP in SD
punctate,nucleolus97.5612 -
N' TEF2pr-mCherry in SD

punctate,nucleolus47.6408 -
N' NATIVEpr-GFP in SD
nucleolus62.0487 -
N' TEF2pr-VC and Cyto-VN in SD
nucleolus38.2547 -
C’ GFP library in SD+DTT

nucleolus76.090.79No -
C’ GFP library in SD+H2O2

nucleolus76.80.8No -
C’ GFP library in Starvation Media
nucleolus51.270.53Yes -
C’ GFP library on the background of Pup2-DaMP

N/A -
C’ GFP library on the background of CCT mutant

N/A0N/AYes
